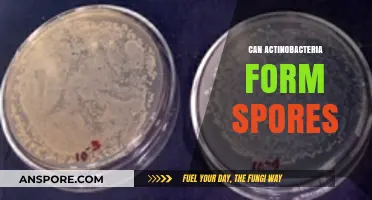
Do Actinobacteria Produce Spores? Unveiling Their Survival Strategies

Apple cider vinegar (ACV) is often touted as a natural remedy for various ailments, including skin conditions like ringworm. Ringworm, a fungal infection caused by dermatophytes, can be persistent due to its ability to leave behind spores that may lead to recurring infections. Many people wonder whether ACV, with its acidic and antimicrobial properties, can effectively kill ringworm spores. While anecdotal evidence suggests that ACV may help alleviate symptoms and inhibit fungal growth, scientific research on its ability to specifically target and eliminate ringworm spores remains limited. Its acidic nature may create an unfavorable environment for fungal survival, but it is not a guaranteed solution and should be used cautiously, as undiluted ACV can irritate the skin. For severe or persistent cases, consulting a healthcare professional and using antifungal medications is generally recommended.
| Characteristics | Values |
|---|---|
| Effectiveness | Limited evidence suggests apple cider vinegar (ACV) may have antifungal properties, but it is not proven to kill ringworm spores effectively. |
| Mechanism | ACV’s acidity (acetic acid) may create an unfavorable environment for fungal growth, but it does not penetrate deeply enough to target spores. |
| Scientific Studies | No conclusive studies specifically confirm ACV’s ability to kill ringworm spores; most evidence is anecdotal or based on general antifungal properties. |
| Application | Topical use (diluted ACV) may help manage symptoms but is not a reliable treatment for ringworm or its spores. |
| Safety | Generally safe when diluted, but undiluted ACV can cause skin irritation or chemical burns. |
| Alternative Treatments | Antifungal medications (e.g., clotrimazole, terbinafine) are more effective for treating ringworm and killing spores. |
| Prevention | ACV may help maintain skin pH, but it is not a proven method to prevent ringworm infections or spore survival. |
| Expert Opinion | Dermatologists recommend proven antifungal treatments over home remedies like ACV for ringworm. |
| Cost | Inexpensive and accessible, but not a substitute for medical treatment. |
| Availability | Widely available in households and stores, but not specifically formulated for fungal infections. |
Explore related products
$7.75 $8.99
$9.73 $11.45
What You'll Learn

ACV's antifungal properties against ringworm spores
Apple cider vinegar (ACV) has long been touted for its antimicrobial properties, but its effectiveness against ringworm spores specifically is a nuanced topic. Ringworm, caused by a fungal infection, thrives in warm, moist environments and can be stubborn to eradicate. ACV’s acetic acid content is believed to disrupt fungal cell membranes, potentially inhibiting growth. However, while anecdotal evidence supports its use, scientific studies on ACV’s direct impact on ringworm spores remain limited. This gap highlights the need for caution when relying solely on ACV as a treatment, especially for severe or persistent infections.
To use ACV for ringworm, dilute it with water in a 1:1 ratio to avoid skin irritation, as undiluted ACV can be harsh. Apply the solution to the affected area using a cotton ball, leaving it on for 15–20 minutes before rinsing. Repeat this process twice daily for at least one week. For scalp ringworm, consider adding a few tablespoons of diluted ACV to a final hair rinse after shampooing. While this method may help manage symptoms, it’s not a substitute for antifungal medications prescribed by a healthcare professional.
Comparatively, ACV’s antifungal action is often contrasted with over-the-counter treatments like clotrimazole or terbinafine, which target fungal spores more directly. Unlike these medications, ACV’s effectiveness varies based on factors like concentration, application method, and individual skin sensitivity. For instance, children or those with sensitive skin may experience irritation from ACV, making it less practical for certain age groups or skin types. This variability underscores the importance of monitoring skin reactions and adjusting usage accordingly.
A descriptive perspective reveals ACV’s potential as a complementary remedy rather than a standalone cure. Its acidic nature creates an unfavorable environment for fungal growth, but ringworm spores are resilient and may require more targeted interventions. Combining ACV with other natural antifungals, such as tea tree oil, could enhance its efficacy, though this approach lacks clinical validation. Practical tips include maintaining dry skin, avoiding shared personal items, and disinfecting surfaces to prevent reinfection while using ACV.
In conclusion, while ACV’s antifungal properties offer a promising natural alternative for managing ringworm, its limitations must be acknowledged. It can be a useful adjunctive treatment for mild cases, particularly when paired with proper hygiene practices. However, for severe or persistent infections, consulting a healthcare provider for prescription antifungals remains the most reliable course of action. ACV’s role lies in its accessibility and potential to alleviate symptoms, but it should not replace evidence-based treatments.
Inhaling Spores: Understanding the Risks and Potential Health Impacts
You may want to see also

Effectiveness of ACV in spore eradication
Apple cider vinegar (ACV) is often touted as a natural remedy for various ailments, including fungal infections like ringworm. Its acidic nature, primarily due to acetic acid, is believed to create an inhospitable environment for fungi. However, when it comes to eradicating ringworm spores, the effectiveness of ACV is not as straightforward as many anecdotal claims suggest. Spores are highly resilient structures designed to survive harsh conditions, and while ACV may inhibit fungal growth, its ability to fully eradicate spores remains scientifically unproven.
To use ACV as a potential spore-fighting agent, dilute it with water in a 1:1 ratio to avoid skin irritation. Apply the solution directly to the affected area using a cotton ball, leaving it on for 15–20 minutes before rinsing. Repeat this process twice daily for at least two weeks. While this method may help manage active ringworm infections by targeting the fungus, it is unlikely to penetrate spores deeply enough to destroy them. Spores require more aggressive antifungal agents or extreme conditions, such as high heat, to be neutralized effectively.
Comparatively, medical treatments like topical antifungal creams (e.g., clotrimazole or miconazole) or oral medications (e.g., terbinafine) are far more reliable for eradicating both active infections and spores. These treatments are specifically formulated to target fungal cell membranes and disrupt spore viability. ACV, while useful as a complementary remedy, should not replace evidence-based therapies, especially in severe or persistent cases. Its role is better suited for mild infections or as a preventive measure rather than a spore-eradication solution.
For those considering ACV, it’s essential to monitor the skin for irritation or allergic reactions, particularly in children or individuals with sensitive skin. If redness, itching, or burning occurs, discontinue use immediately. Additionally, ACV should not be applied to open wounds or broken skin, as its acidity can exacerbate discomfort. While its antifungal properties offer some benefits, managing expectations and understanding its limitations in spore eradication are crucial for effective ringworm treatment.
Rainstorms and Airborne Spores: Can Heavy Downpours Cleanse the Air?
You may want to see also

ACV application methods for ringworm treatment
Apple cider vinegar (ACV) is often touted as a natural remedy for various ailments, including ringworm, due to its acidic nature and potential antifungal properties. While scientific evidence is limited, anecdotal reports suggest ACV may help combat ringworm by creating an inhospitable environment for the fungus. However, its effectiveness against ringworm spores, which are more resilient than active infections, remains uncertain. When considering ACV for ringworm treatment, the application method is crucial for maximizing potential benefits while minimizing risks.
Direct Topical Application: One of the most common methods involves diluting ACV with water (typically a 1:1 ratio) and applying it directly to the affected area using a cotton ball or clean cloth. This approach allows the acetic acid in ACV to come into direct contact with the infection. For best results, leave the solution on for 15–20 minutes before rinsing with water. Repeat this process 2–3 times daily. Caution: Undiluted ACV can cause skin irritation, especially in children or those with sensitive skin. Always perform a patch test before full application.
Soaking Method: For larger affected areas or nail infections, soaking in an ACV solution can be more practical. Add 1 cup of ACV to a basin of warm water and soak the affected area for 15–20 minutes daily. This method is gentler and may be suitable for individuals with widespread ringworm. However, it may be less effective against deeply embedded spores. For added benefit, combine ACV with antifungal essential oils like tea tree oil, but use sparingly to avoid skin irritation.
Oral Consumption: While less common, some advocate for ingesting diluted ACV (1–2 tablespoons in a glass of water) to combat ringworm from within. This method is based on the idea that ACV can create an acidic internal environment that discourages fungal growth. However, scientific evidence supporting this approach is lacking, and excessive consumption can harm tooth enamel or irritate the digestive tract. Consult a healthcare provider before trying this method, especially for children or those with pre-existing conditions.
Combination Therapy: For optimal results, ACV is often used alongside conventional antifungal treatments. Apply ACV topically after cleaning the affected area, followed by an over-the-counter antifungal cream like clotrimazole. This dual approach may enhance efficacy by targeting both active fungal growth and potential spores. However, monitor for signs of irritation, as combining treatments can increase the risk of skin reactions.
In conclusion, while ACV application methods for ringworm treatment vary, each has its merits and limitations. Topical and soaking methods are generally safe and practical for localized infections, but their effectiveness against spores is uncertain. Oral consumption remains controversial and should be approached with caution. Combining ACV with conventional treatments may yield better results but requires careful monitoring. Always prioritize hygiene, such as washing hands and disinfecting surfaces, to prevent reinfection and spore spread.
Crafting Spore Blossoms: Possibilities, Methods, and Creative Applications Explored
You may want to see also
Explore related products
$13.99 $14.98

Scientific evidence supporting ACV's spore-killing ability
Apple cider vinegar (ACV) has long been touted as a natural remedy for various ailments, but its efficacy against ringworm spores remains a topic of scientific inquiry. While anecdotal evidence abounds, rigorous studies specifically targeting ACV’s ability to kill ringworm spores are limited. However, its antimicrobial properties, primarily attributed to acetic acid, suggest potential spore-killing capabilities. Acetic acid, which constitutes about 5% of ACV, has been shown to disrupt cell membranes and denature proteins in fungi, mechanisms that could theoretically extend to spores.
One study published in the *Journal of Prosthodontics* (2014) demonstrated that acetic acid effectively inhibits the growth of *Candida albicans*, a fungus related to dermatophytes like *Trichophyton*, which causes ringworm. While this study did not directly test ringworm spores, it provides a foundation for understanding ACV’s antifungal potential. Additionally, a 2018 review in *Scientific Reports* highlighted acetic acid’s ability to reduce biofilm formation in fungi, a process critical for spore survival. These findings, though indirect, imply that ACV could interfere with spore viability.
Practical application of ACV for ringworm treatment often involves diluting it with water (1:1 ratio) and applying it topically to affected areas twice daily. For pets, a similar dilution can be used, but caution is advised to avoid skin irritation. While these methods are widely shared, their effectiveness against spores specifically remains unproven in clinical trials. It’s crucial to note that ACV should not replace antifungal medications, especially for severe or persistent infections.
Comparatively, established antifungal agents like clotrimazole and terbinafine have been rigorously tested against ringworm spores, demonstrating consistent efficacy. ACV, while promising, lacks such definitive evidence. Its use should be considered complementary rather than primary, particularly for immunocompromised individuals or those with extensive infections.
In conclusion, while scientific evidence supports ACV’s general antifungal properties, its specific ability to kill ringworm spores remains speculative. Further research is needed to validate its efficacy in this context. Until then, ACV can be a safe, natural adjunct to conventional treatments, provided it is used correctly and in moderation. Always consult a healthcare professional before relying solely on home remedies for fungal infections.
Nematodes and Milky Spore: Unraveling Their Relationship in Soil Health
You may want to see also

Potential risks of using ACV on ringworm
Apple cider vinegar (ACV) is often touted as a natural remedy for various ailments, including ringworm. However, its acidic nature raises concerns about potential risks when applied to the skin. While ACV’s acetic acid may inhibit fungal growth, its concentration (typically 5-6% in undiluted form) can cause skin irritation, especially in sensitive areas like the face, groin, or underarms. Direct application without dilution can lead to redness, burning, or chemical burns, particularly in children or individuals with compromised skin barriers.
Consider the method of application: undiluted ACV should never be used directly on the skin. For topical use, dilute 1 tablespoon of ACV in 1 cup of water. Even then, perform a patch test on a small area of skin to check for adverse reactions before applying it to the affected area. Prolonged or frequent use of ACV, even diluted, can disrupt the skin’s natural pH, potentially worsening irritation or delaying healing. This is especially critical for ringworm on sensitive skin or in individuals with conditions like eczema.
Another risk lies in ACV’s potential to interact with medications or existing skin treatments. For instance, combining ACV with topical antifungal creams may increase the risk of skin irritation or reduce the effectiveness of either treatment. If you’re using prescription medications or over-the-counter antifungals, consult a healthcare provider before incorporating ACV into your regimen. Self-treatment with ACV alone, without medical advice, may also delay proper diagnosis and treatment, allowing the infection to spread or persist.
Finally, while ACV may have antifungal properties, its effectiveness against ringworm spores remains uncertain. Ringworm spores are resilient, and relying solely on ACV could lead to incomplete eradication of the fungus. This is particularly concerning for immunocompromised individuals or those with severe infections, where professional treatment is essential. Always prioritize evidence-based antifungal treatments and use ACV, if at all, as a complementary measure under guidance.
Are Botulism Spores Dangerous? Understanding Risks and Prevention Tips
You may want to see also
Frequently asked questions
Apple cider vinegar has antifungal properties that may help combat ringworm, but there is limited scientific evidence to confirm it can kill ringworm spores specifically.
Dilute apple cider vinegar with water (1:1 ratio) and apply it to the affected area using a cotton ball, 2-3 times daily. Avoid undiluted vinegar, as it can irritate the skin.
No, apple cider vinegar is not a substitute for prescribed antifungal medications. It may be used as a complementary remedy, but consult a healthcare professional for proper treatment.